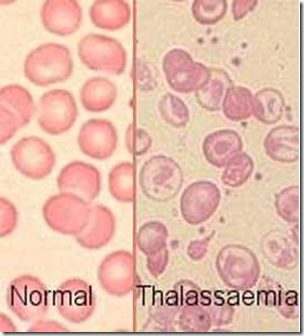

Hereditas pada manusia mempelajari mengenai macam penurunan sifat/kelainan pada manusia. Penurunan sifat pada manusia dibedakan menjadi dua, yaitu sifat yang terpaut koromosom tubuh (autosomal), dan sifat yang terpaut kromosom sex (gonosomal). Sifat yang autosomal manifestasinya dapat muncul baik pada anak laki-laki maupun perempuan. Sedangkan sifat yang gonosomal manifestasinya dipengaruhi oleh jenis kelamin, bisa hanya muncul pada anak laki-laki saja atau perempuan saja.
Sifat/Cacat Menurun Autosomal
Beberapa sifat/cacat menurun yang terpaut pada kromosom tubuh (autosom) adalah sebagai berikut.
1. Albinisme




Banyak kasus albinisme pada berbagai hewan dan manusia
Albinisme merupakan cacat menurun dimana seseorang tidak mempunyai tirosin yang akan diubah menjadi pigmen melanin. Akibatnya alis, rambut, dan kulit tampak putih (albino), dan matanya peka terhadap cahaya. Gen penyebab albino bersifat resesif, sedangkan alel dominannya mengendalikan sifat normal. Seorang anak albino lahir dari pasangan suami isteri yang masing-masing membawa gen albino (carrier)
Albinisme merupakan cacat menurun dimana seseorang tidak mempunyai tirosin yang akan diubah menjadi pigmen melanin. Akibatnya alis, rambut, dan kulit tampak putih (albino), dan matanya peka terhadap cahaya. Gen penyebab albino bersifat resesif, sedangkan alel dominannya mengendalikan sifat normal. Seorang anak albino lahir dari pasangan suami isteri yang masing-masing membawa gen albino (carrier)
P : Aa x Aa
F : AA : normal
2Aa : normal (carrier)
aa : albino
2Aa : normal (carrier)
aa : albino
2. Idiot/Imbisil
Cacat menurun ini disebabkan karena seseorang tidak punya enzim yang mengubah fenilalanin menjadi tirosin. Akibatnya terjadi penimbunan fenilalanin dalam darah dan diubah menjadi asam fenilpiruvat. Tingginya kadar fenilpiruvat menghambat perkembangan dan fungsi otak. Kelainan ini sering disebut phenilketouria (PKU) karena banyaknya kandungan residu fenilpiruvat yang terdapat pada urine.
Anak yang idiot/imbisil memiliki ciri sebagai berikut:
- IQ rendah
- gerakan lambat
- rambut sering kekurangan pigmen
- dalam urine dijumpai residu fenilpiruvat
Seorang anak idiot dilahirkan dari pasangan suami isteri yang keduanya membawa gen resesif.
P : Ii x Ii
F : II : normal
2Ii : normal (carrier)
ii : idiot
2Ii : normal (carrier)
ii : idiot
3. Thallasemia
Thallasemia merupakan kelainan dimana sel darah merah seseorang berbentuk tidak beraturan, kadar Hb sedikit sehingga penderita sering kekurangan oksigen (hipoksemia). Cacat ini disebabkan oleh gen dominan.
Ada dua jenis thallasemia, yaitu thallasemia mayor (ThTh) dan thallasemia minor (Thth). Sel darah merah penderita thallasemia mayor semua berbentuk tidak beraturan dan umumnya lethal. Sedangkan pada penderita thallasemia minor sebagian sel darah merahnya berbentuk tak beraturan. Penderita bisa bertahan hidup dengan melakukan transfusi reguler.
Penderita thallasemia mayor lahir dari perkawinan antar penderita thallasemia minor.
P : Thth x Thth
F : ThTh : thallasemia mayor
2Thth : thallasemia minor
thth : normal
4. Golongan Darah

Ada banyak klasifikasi golongan darah, diantaranya adalah golongan ABO, Rhesus, dan MN. Dua yang pertama memiliki nilai medis, sedang yang terakhir tidak. Ketiga golongan tersebut ditemukan oleh K. Landsteiner.
Golongan ABO
Golongan ini membagi golongan darah menjadi empat, yaitu A, B, AB, dan O, didasarkan pada adanya jenis antigen tertentu pada sel darah yang disebut isoaglutinogen. Susunan genotif dan kemungkinan gamet yang dibentuk dapat dilihat pada tabel berikut.

Golongan darah ABO dikendalikan oleh alela ganda IA, IB, dan IO. IA dan IB kodominan, dan keduanya dominan terhadap IO.
Contoh: perkawinan antara pria golongan A heterozigot dengan wanita B heterozigot.
P : IAIO x IBIO
G : IA , IO IB , IO
F : IAIB : golongan AB
IAIO : golongan A
IBIO : golongan B
IOIO : golongan O
Golongan Rhesus
Golongan ini dinamakan berdasar nama kera dari India, Macacus rhesus, yang dulu sering digunakan untuk mengetes darah orang.
Golongan darah ini ada dua yaitu Rhesus + dan Rhesus -. Susunan genotif dan kemungkinan gamet dapat dilihat pada tabel berikut.
Golongan Rhesus ini memiliki arti penting pada perkawinan. Bila seorang pria Rhesus + menikah dengan wanita Rhesus -, kemungkinan anaknya menderita eritroblastosis fetalis (penyakit kuning bayi).
Contoh: perkawinan antara pria Rh + dengan wanita Rh -
P : pria Rhesus + x wanita Rhesus –
RhRh rhrh
G : Rh rh
F : Rhrh Rhesus + (eritroblastosis fetalis)

Kasus eritroblastosis: perhatikan bahwa eritrosit anak golongan Rh+ digumpalkan oleh antibodi ibu (warna putih) yang bergolongan Rh- ketika dalam kandungan
Golongan MN
Golongan ini tidak memiliki nilai medis karena hanya dijumpai antigen penentu golongan dalam eritrosit dan tidak dijumpai antibodi dalam plasma.
Golongan ini dikendalikan oleh gen IM dan IN kodominan satu sama lain. Susunan genotif dan kemungkinan gamet dapat dilihat pada tabel berikut.

Contoh: perkawinan antara pria golongan M (homozigot) dengan wanita golongan N (homozigot)
P : pria golongan M x wanita golongan N
IMIM ININ
G : IM IN
F : IMIN : golongan MN
Sifat/Cacat Menurun Gonosomal
Sifat yang diturunkan terpaut kromosom sex (gonosom) dibedakan menjadi dua, yaitu terpaut kromosom X dan terpaut kromosom Y. Gen yang terpaut kromosom X dapat diturunkan pada anak perempuan dan anak laki-laki, tetapi fenotif yang muncul bergantung pada susunan genotifnya. Sedangkan gen yang terpaut kromosom Y hanya diturunkan pada anak laki-laki.
1. Cacat menurun yang terpaut kromosom X
Dua contoh cacat menurun yang terpaut kromosom X adalah hemofili dan butawarna.
a. Hemofili

Hemofili merupakan suatu kelainan dimana darah seseorang sulit untuk membeku. Penyakit ini disebabkan gen resesif h, sedangkan sifat normal dikendalikan oleh gen H. Seorang wanita normal memiliki dua gen H pada masing-masing kromosom X. Bila salah satu kromosom X terdapat gen h, wanita ini termasuk wanita normal tetapi membawa sifat hemofili (carrier). Bila pada kedua kromosom X terdapat gen h wanita tersebut menderita hemofili dan umumnya lethal. Pria menderita hemofili bila pada kromosom X-nya terdapat gen h, dan normal bila terdapat gen H. Seorang anak laki-laki hemofili dapat lahir dari ibu carrier.

Ratu Victoria dari Kerajaan Inggris
Menurut sejarah, wanita pertama carrier hemofili adalah Ratu Victoria. Disebut pertama karena silsilah di atas Ratu Vicotria tidak diketahui. Pangeran Andrew mewarisi gen ini dari ibunya dan meninggal saat kecelakaan dengan luka yang tidak seberapa parah.
P : pria normal x wanita carrier
XHY XHXh
G : XH, Y XH, Xh
F : XHXH : wanita normal XHY : pria normal
XHXh : wanita normal carrier Xhy : pria hemofili
XHXh : wanita normal carrier Xhy : pria hemofili
2. Butawarna (colorblind)

Angka berapa ya?

Gambar apa nih?
Butawarna merupakan cacat menurun dimana seseorang tidak bisa membedakan warna. Umumnya tidak bisa membedakan warna merah dan hijau (dikromatis). Sedangkan pada butawarna total orang tidak bisa melihat warna. Kelainan ini juga disebabkan gen resesif c, sedangkan sifat normal dikendalikan gen dominan C.
Anak perempuan buta warna dapat dilahirkan dari pria butawarna yang menikah dengan wanita carrier.
P : pria butawarna x wanita carrier
XcY XCXc
G : Xc, Y XC, Xc
F : XCXc : wanita normal carrier
XcXc : wanita butawarna
XCY : pria normal
XcY : pria butawarna
XcXc : wanita butawarna
XCY : pria normal
XcY : pria butawarna
2. Cacat menurun yang terpaut kromosom Y
Gen-gen yang terpaut pada kromosom Y hanya diwariskan pada anak laki-laki, oleh karena itu sering disebut sebagai gen holandrik.
Contoh dari cacat yang terpaut kromosom Y adalah: hypertrichosis, hystrixgraviour, dan webbedtoes. Ketiganya disebabkan oleh gen resesif.
Hypertrichosis

Seorang pria dengan hypertrichosis
Gen ht yang terdapat pada kromosom Y menyebabkan tumbuhnya rambut di tepi daun telinga. Kelainan seperti ini banyak dijumpai pada para pria Pakistan.
P : XYht x XX
F : XYht : laki-laki hypertrichosis
XYht : laki-laki hypertrichosis
XYht : laki-laki hypertrichosis
Hystrixgraviour
Kelainan ini disebabkan oleh gen hg yang menyebabkan tumbuhnya rambut panjang dan kaku di seluruh tubuh (penyakit bulu landak). Sifat normal dikendalikan gen Hg.
Webbedtoes
Merupakan kelainan dimana pada jari terutama kaki tumbuh selaput seperti kaki katak. Penyebabnya adalah gen wt, sedangkan sifat normal dikendalikan gen Wt
No comments:
Post a Comment